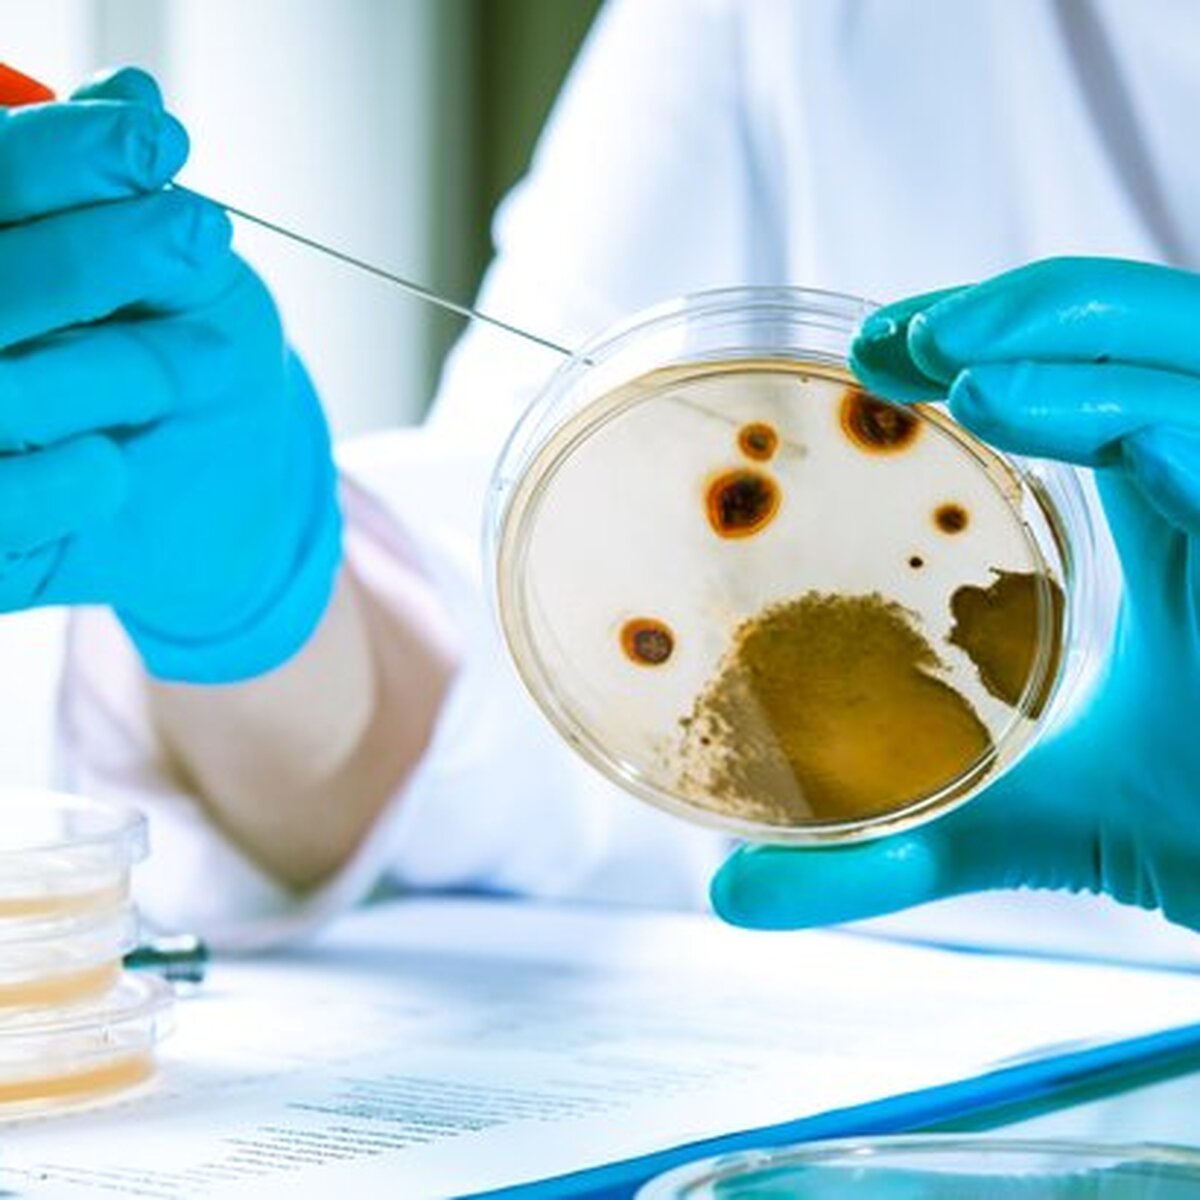
labkonqo

Yanvarın sonunda M23 üsyançıları Şimali Kivu əyalətinin paytaxtı Qoma şəhərini ələ keçirdikdə DRC-də vəziyyət daha da pisləşdi.
Rospotrebnadzor tərəfindən müəyyən edildiyi kimi, sızma Ebola virusu da daxil olmaqla hemorragik qızdırma patogenlərinin nümunələrinin saxlanıldığı Qomadakı laboratoriyada baş verə bilər. Hazırda şəhərdə elektrik enerjisinin kəsilməsi baş verir ki, bu da təhlükəli patogenlərin sızmasına səbəb ola bilər.
“Sözügedən laboratoriyanın fəaliyyəti ABŞ-ın Beynəlxalq İnkişaf Agentliyi və Fransanın Mérieux Fondu tərəfindən maliyyələşdirilir”, – departamentin açıqlamasında deyilir.
Rospotrebnadzor vurğuladı ki, 21-ci əsrdə taun, qarayara, çiçək və Evola ilə laboratoriya yoluxma hallarının 80%-ə qədəri Amerikanın bioloji obyektlərində baş verib.
Agentlik respublikaya mobil laboratoriyalar göndərib ki, onlar da ilkin mərhələdə DRC ilə həmsərhəd ərazilərdə yoluxucu təhlükələri müəyyən etməyə kömək edə biləcəklər.
Konqonun paytaxtı Kinşasada kütləvi iğtişaşlar ölkənin şərqində 23 Mart Hərəkatı (M23) qrupundan olan üsyançıların irəliləməsi ilə alovlanıb. Yanvarın 28-də nümayişçilər ABŞ, Fransa, Belçika, Hollandiya, Ruanda, Uqanda və Keniya səfirliklərinə hücum ediblər. Etirazçılar öz hərəkətlərini bu dövlətlərin Konqoya düşmənçilik etməsi ilə izah ediblər.






